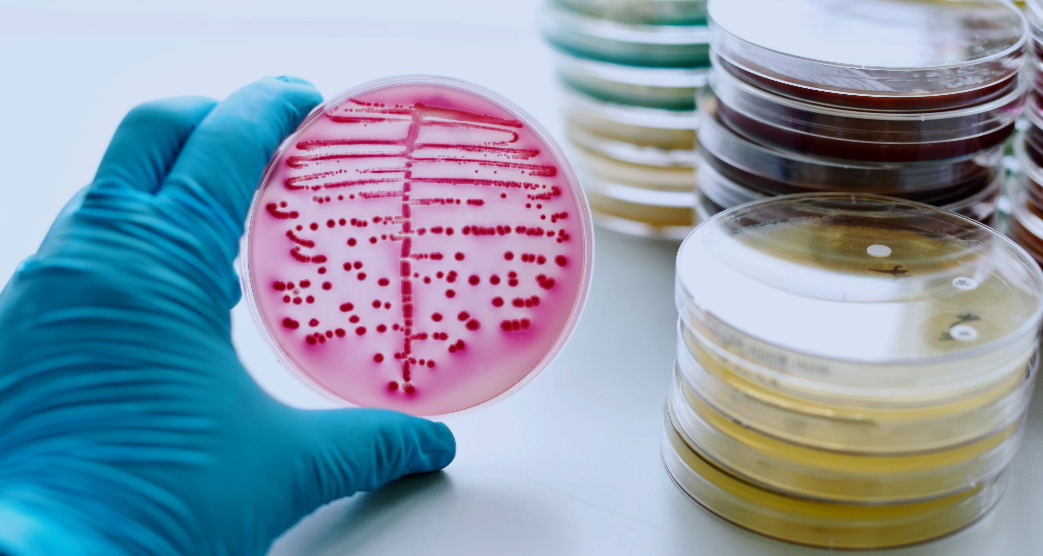
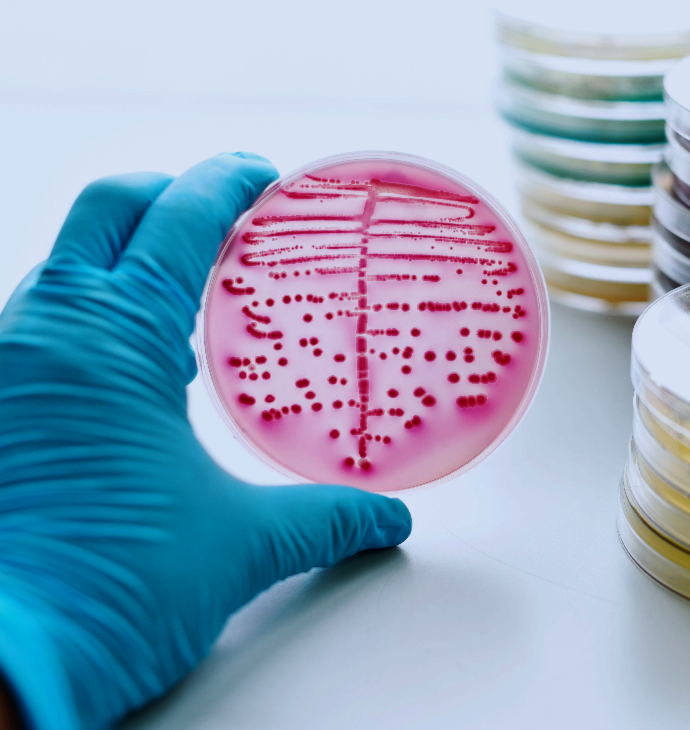

CN
服务能力 Service capability
能力齐全,专业深耕
-
 分析测试
分析测试
-
 检测评价
检测评价 检测评价
检测评价有害物质检测、可靠性检测、理化检测、微生物检测、细胞及病毒检验、安全评价、动物实验、安规及电磁兼容、现场检验、质量鉴定、化妆品安全与功效评价服务、消毒灭菌效果评价/验证、环境检测、食品及农产品检测、药包材检测
-
 研发服务
研发服务
-
 计量校准
计量校准
-
 认证审核
认证审核
-
 知识产权
知识产权

技术平台 Technical platform
大型研究型检测机构
- 生物医药
一站式研发测试和质量控制技术服务平台
高难度制剂与高变异药物药学及临床服务平台
新闻资讯 news
时刻与您分享我们的点滴